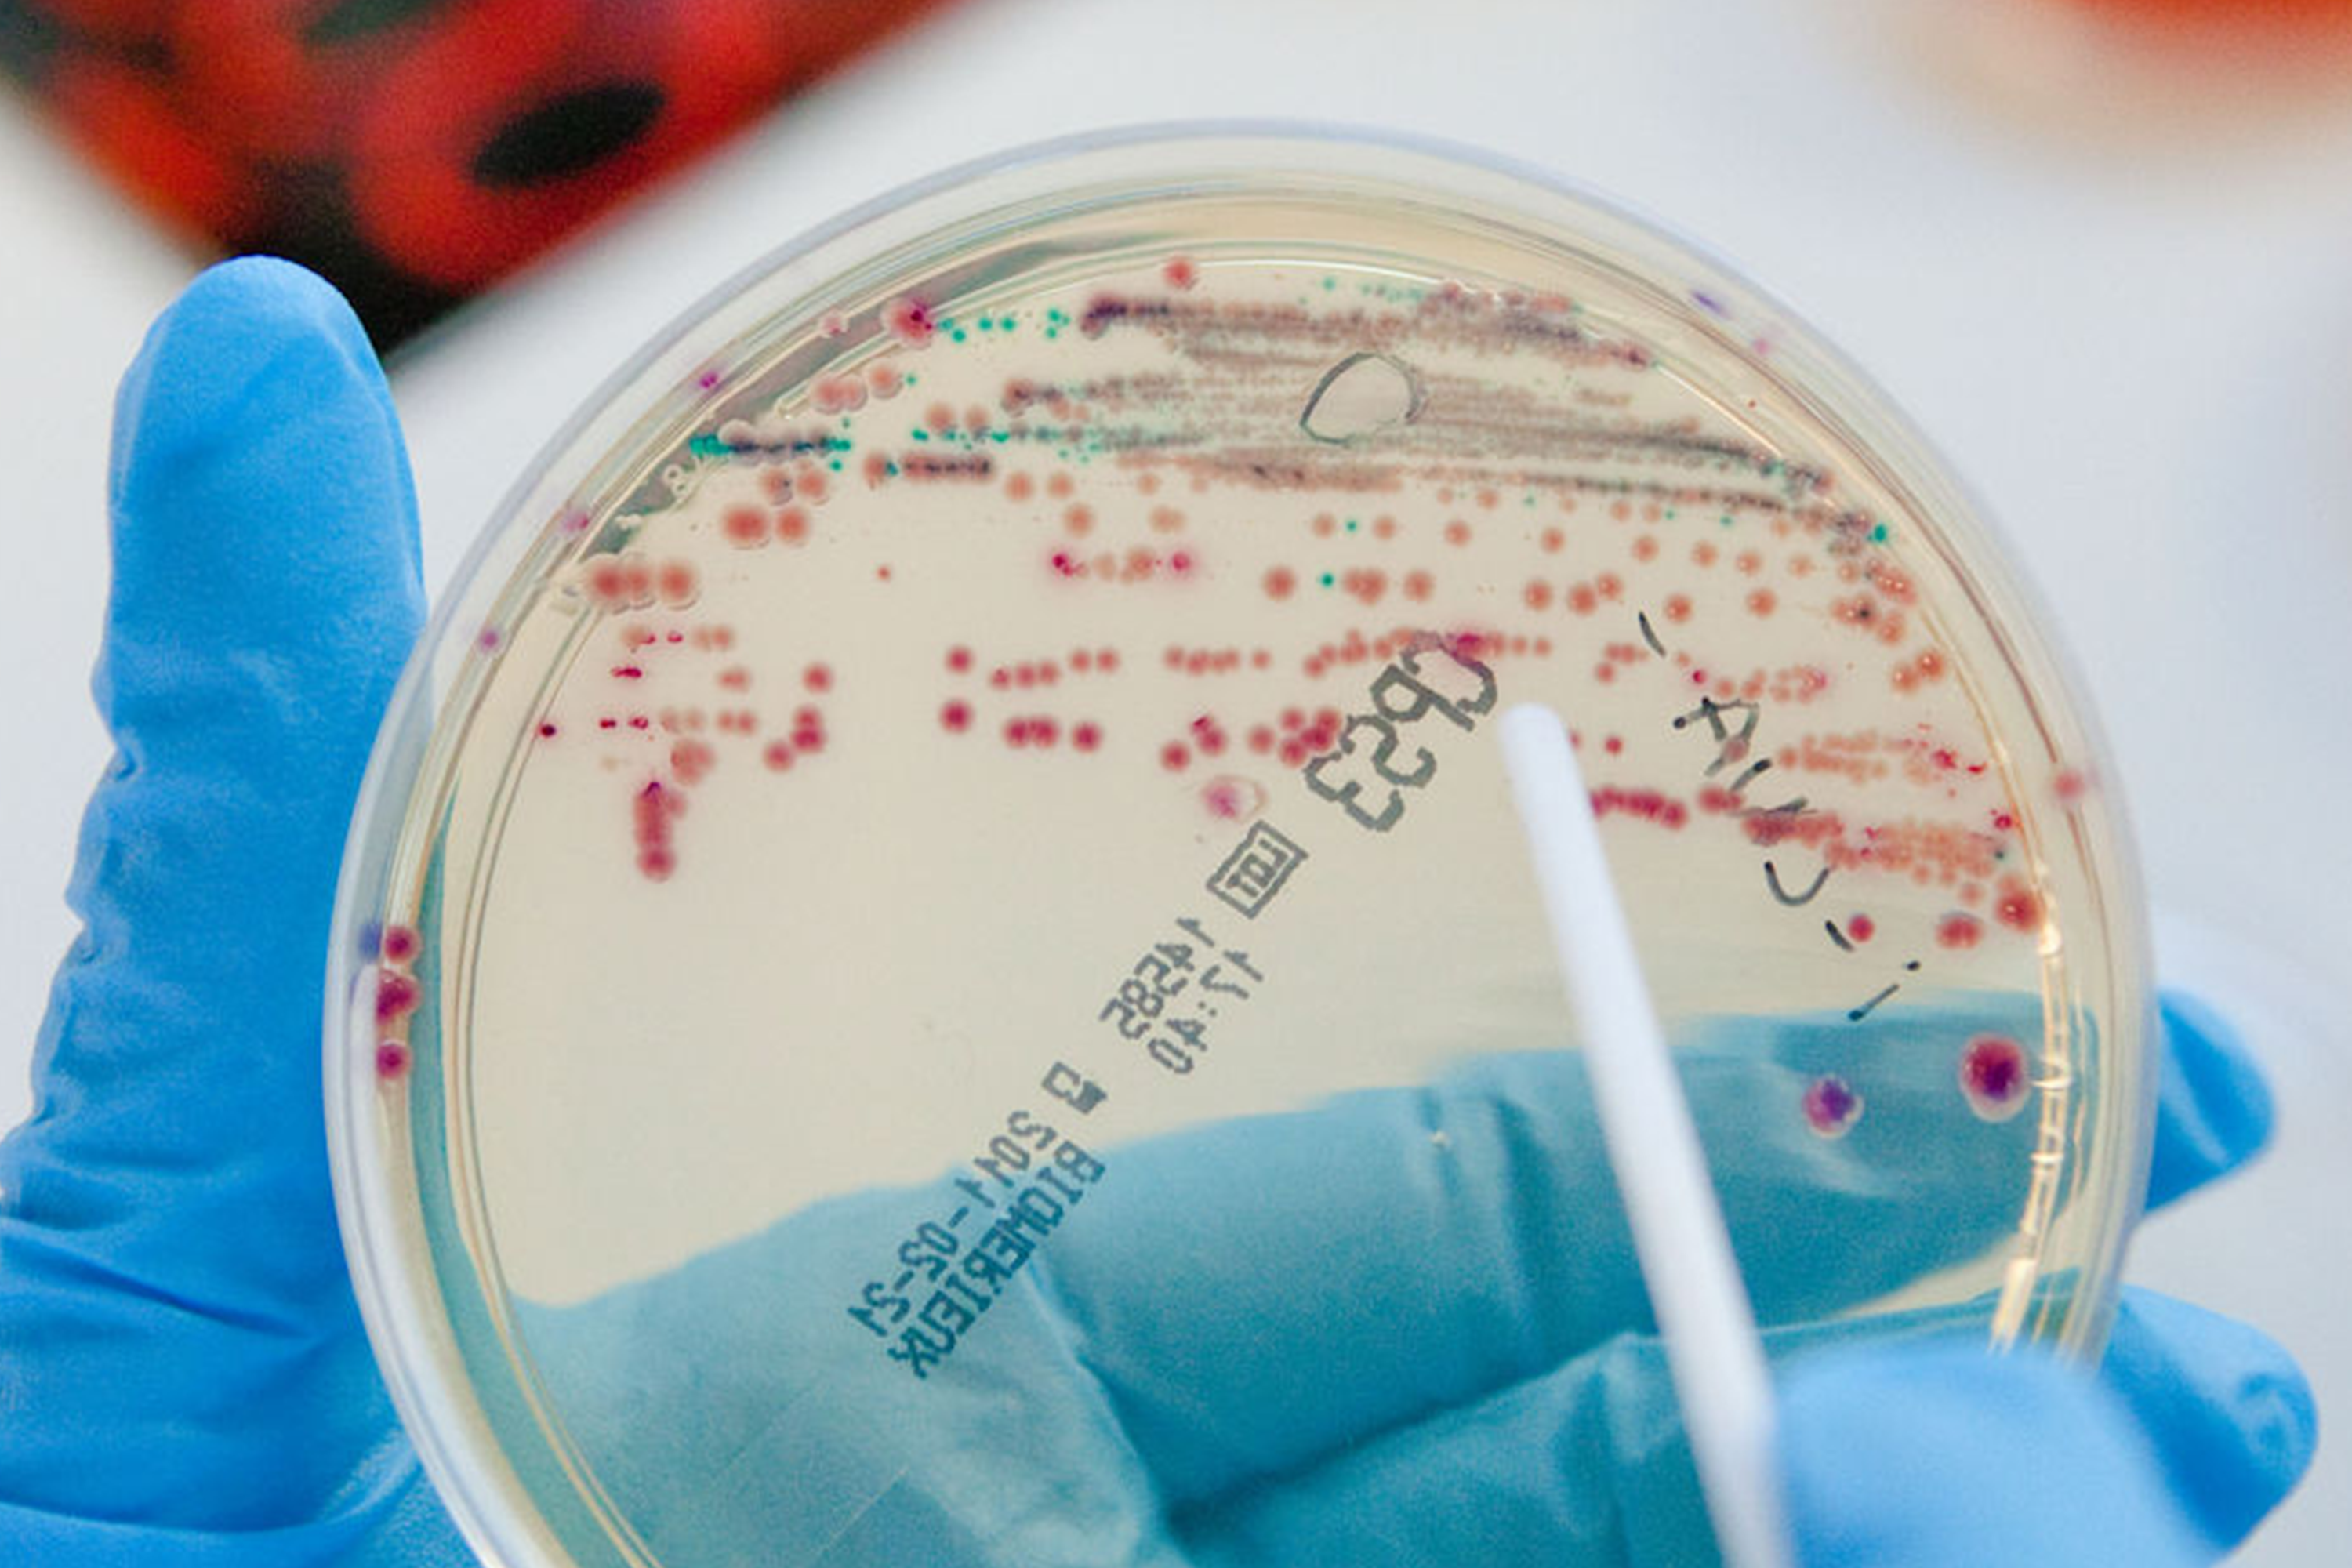
Hand mit blauer Schutzhandschuh hält Petrischale mit Bakterienkulturen zur Überprüfung der Raumluft
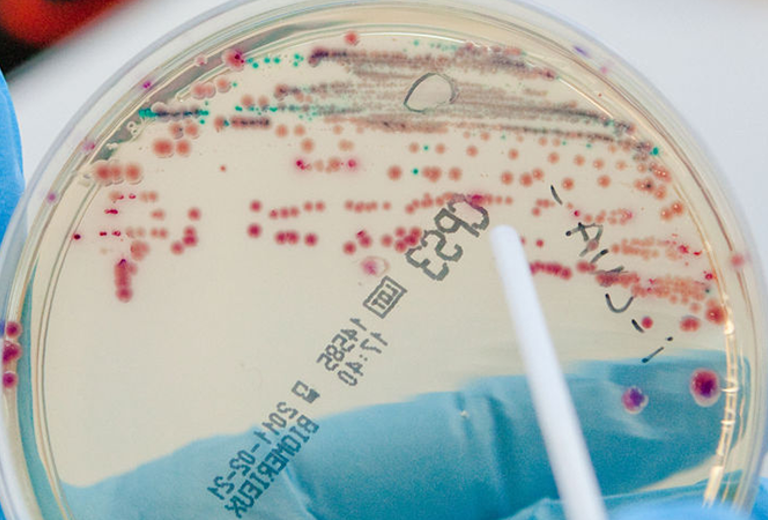
Hand mit blauer Schutzhandschuh hält Petrischale mit Bakterienkulturen zur Überprüfung der Raumluft
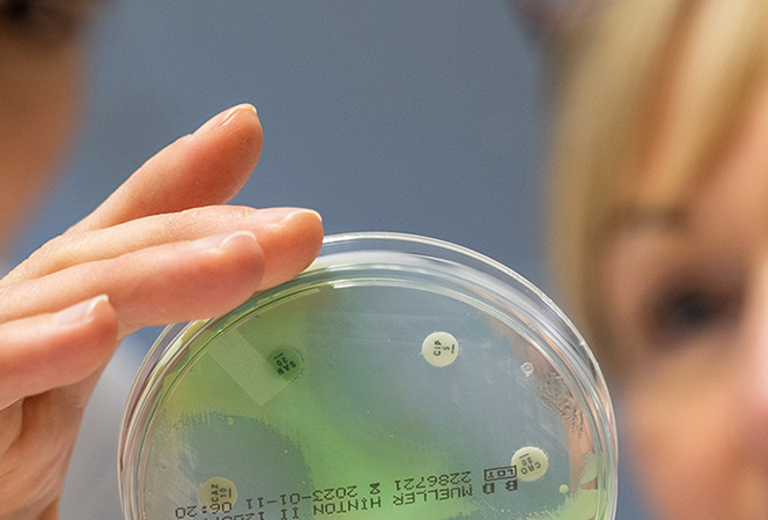
Person hält eine Petrischale mit grünen und weißen Bakterienkulturen zur Umgebungsuntersuchung belebter und unbelebter Oberflächen
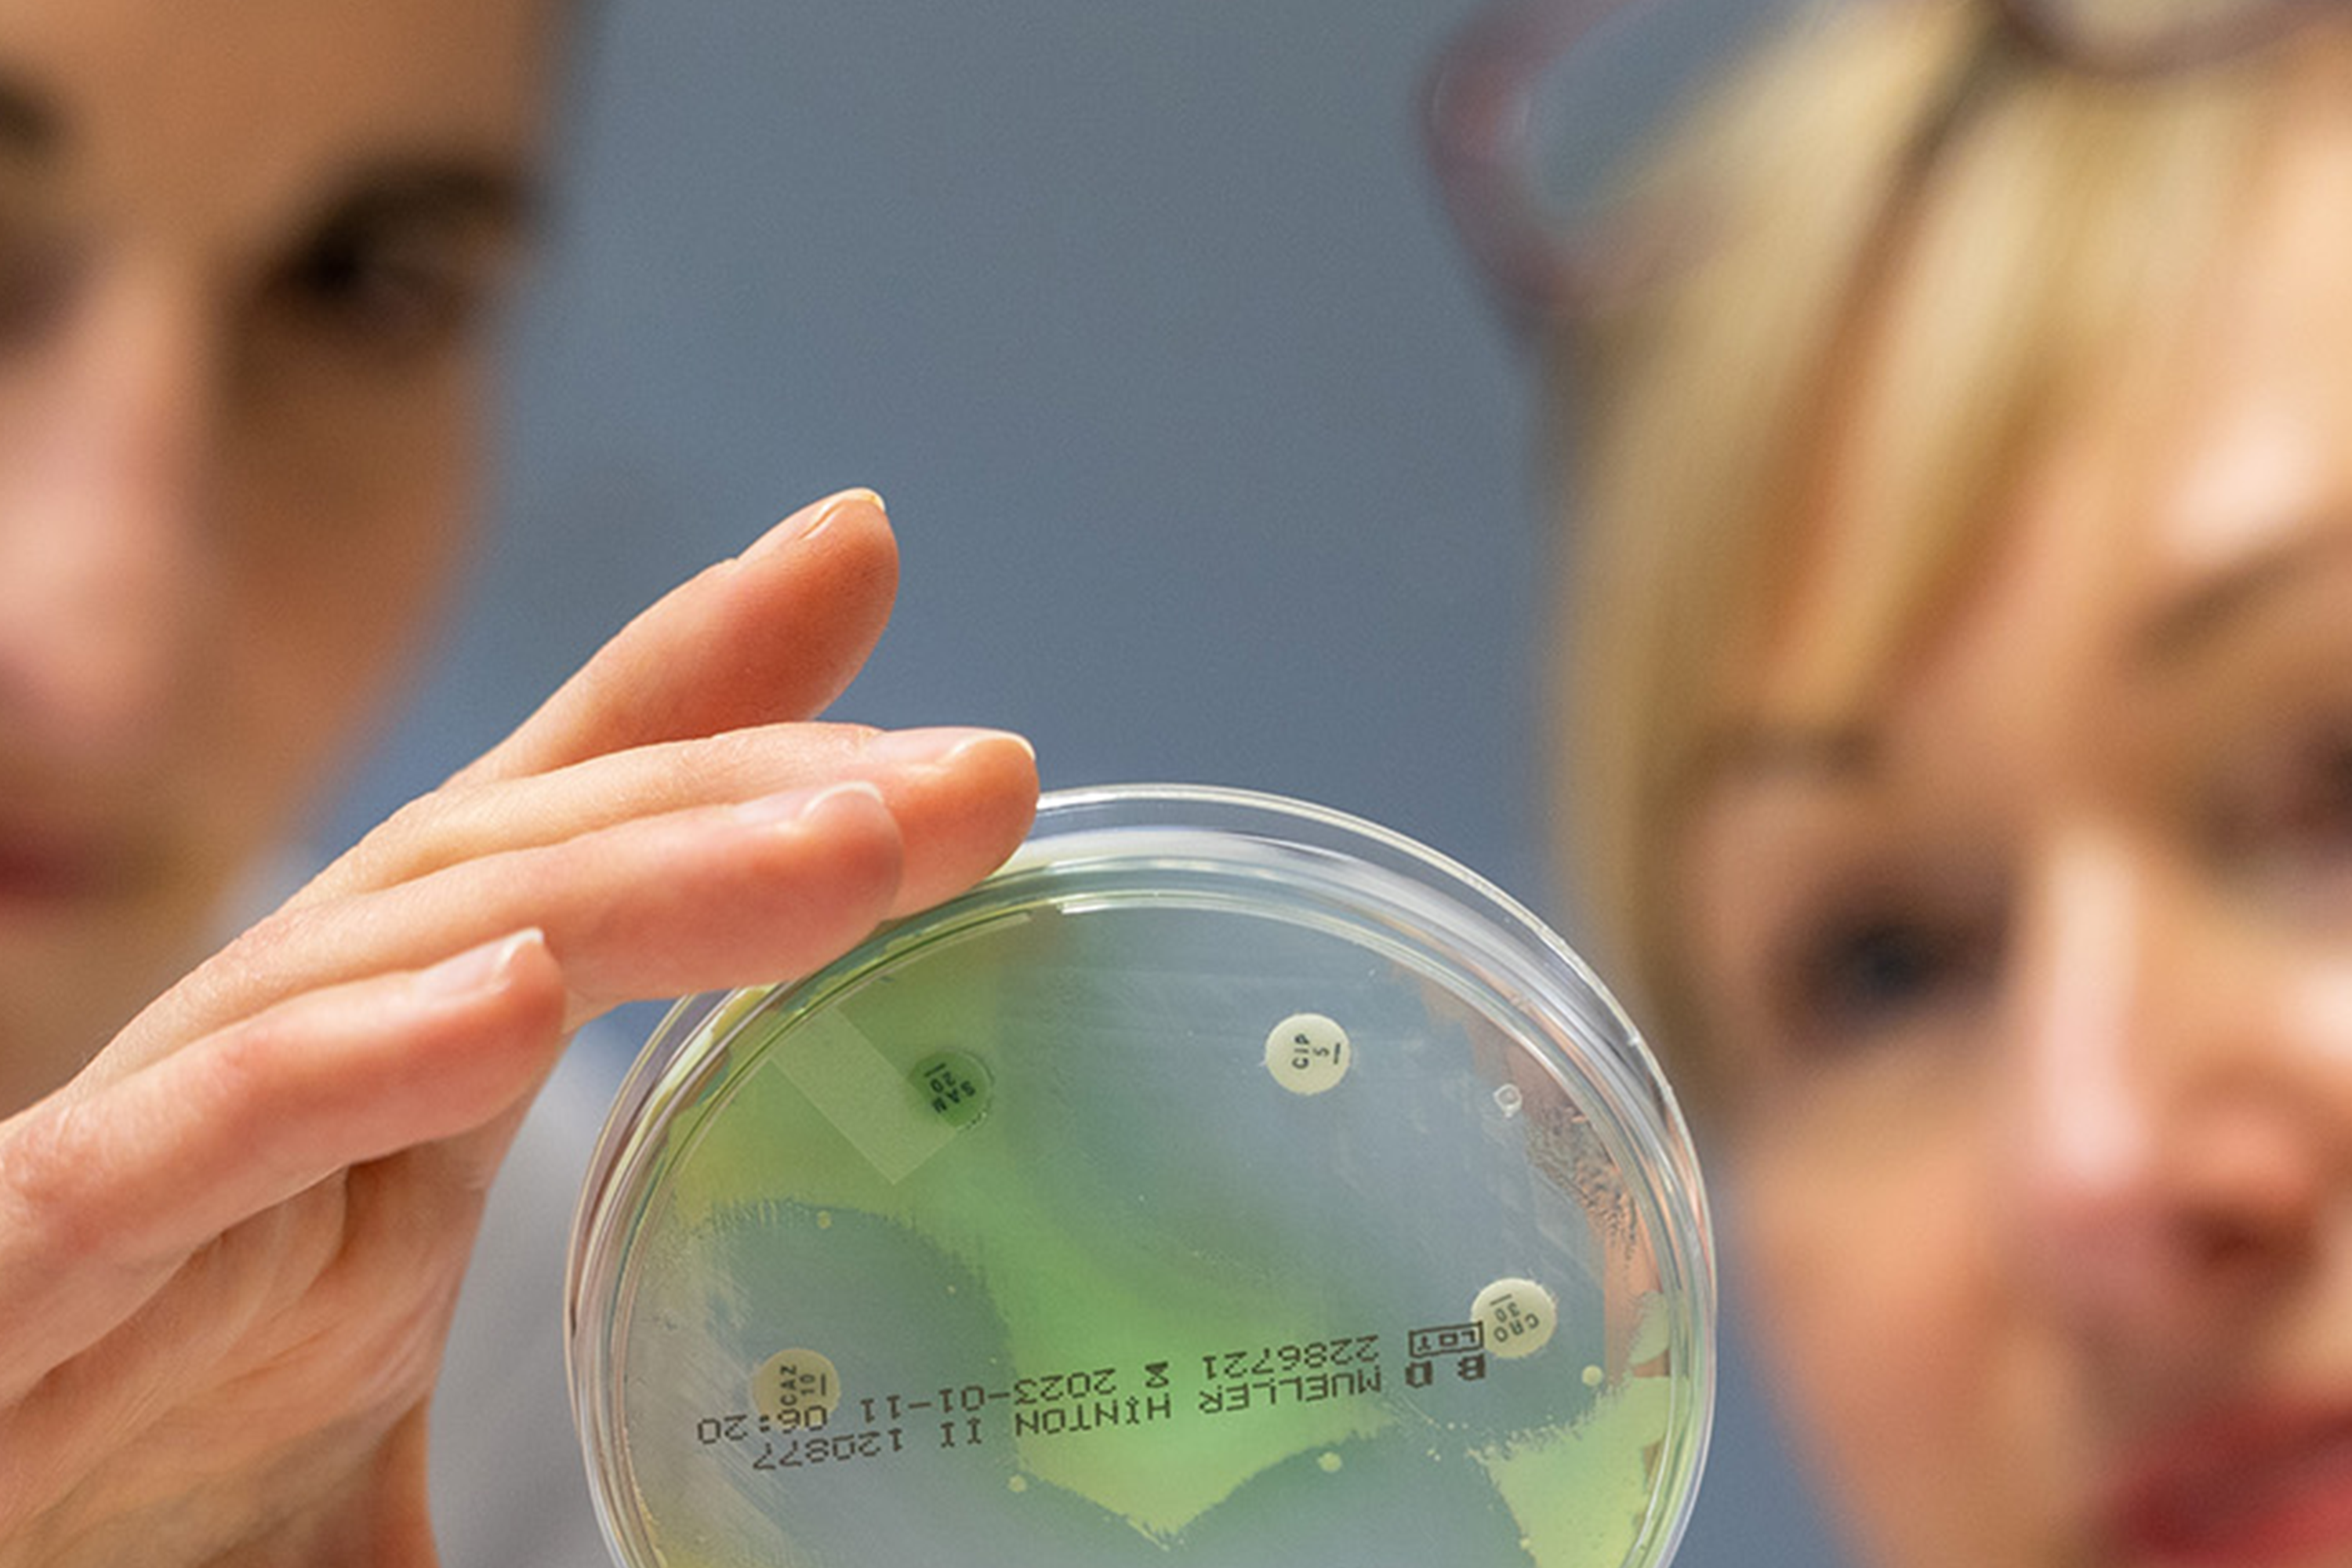
Person hält eine Petrischale mit grünen und weißen Bakterienkulturen zur Umgebungsuntersuchung belebter und unbelebter Oberflächen

Überprüfung der Aufbereitung flexibler Endoskope
Von der Probenahme bis zur Auswertung übernehmen wir die vorgeschriebene halbjährliche Kontrolle Ihrer Endoskope-Aufarbeitung.

Überprüfung der Sterilisationsleistung von Sterilisationsgeräten
Zur ½- bis ¼- jährlichen Kontrolle Ihrer Sterilisationsgeräte stellen wir Ihnen geeignete Bioindikatoren bereit.

Überprüfung der Desinfektionsleistung von Reinigungsdesinfektionsgeräten
Zur Kontrolle Ihrer Reinigungs-Desinfektionsgeräte stellen wir Ihnen geeignete Probematerialien bereit.

Mikrobiologische Wasseruntersuchungen
Ihre Trinkwasserproben werden durch unsere Probenehmer genommen und in unserem nach DIN EN ISO 17025 akkreditierten Labor gemäß der Trinkwasserverordnung analysiert.
> Untersuchung von Wasser zum menschlichen Gebrauch
> Wasserversorgungsanlage und Hausinstallation
> Untersuchung von Trinkwasser auf Legionellen
Überprüfung der Raumluft
Zum Nachweis von Allergien bei Patienten durch Schimmelpilzbelastungen im Wohn- oder Arbeitsbereich bieten sich Raumluftuntersuchungen an.